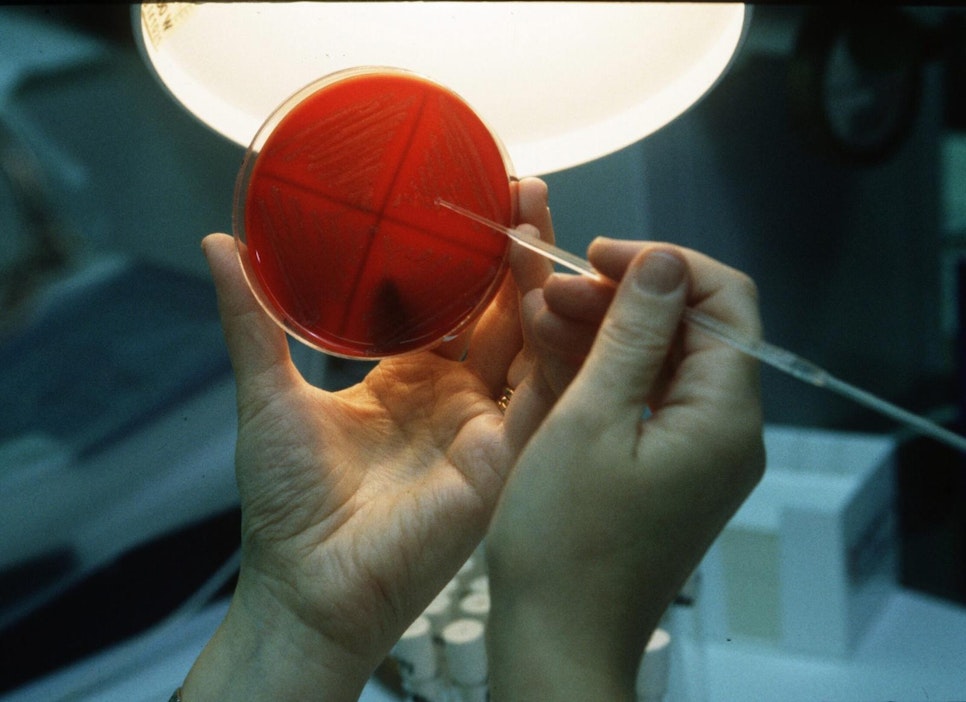
Kuvassa listeriakasvatusalusta.

Eväsleipiä vedetään markkinoilta listeriaepäilyn vuoksi – varotoimena vedetään myös listerialöydöksen jälkeen valmistettuja tuotteita
Takaisinvetoa on laajennettu varotoimenpiteenä koskemaan myös sellaisia tuotteita, jotka on valmistettu samalla tuotantolinjalla listerian saastuttamaksi tiedetyn erän jälkeen.Ruokavirastolle on ilmoitettu tuotteista, jotka niiden valmistajat vetävät myynnistä listeriariskin vuoksi. Raaka-ainevalmistajan yhden tuotteen yhdestä erästä on löytynyt listeriaa. Tämän vuoksi tuotteita vedetään nyt takaisin.
Varotoimenpiteenä takaisinvetoa on laajennettu koskemaan kyseisen erän jälkeen samalla tuotantolinjalla tuotettuja tuotteita ja näistä valmistettuja tuotteita.
Ruokavirastolle on ilmoitettu seuraavista tuotteista:
Härmän SnackPoint Oy, Kinkku-juustorieska, 150 g (viimeinen käyttöpäivä 27.11.19, 2.12.19 ja 4.12.19.)
Kinkku Voileipäkakku, 750 g (viimeinen käyttöpäivä 23.11.19, 26.11.19, 27.11.19, 28.11.19, 30.11.19)
Kinkkukolmari, 150 g (viimeinen käyttöpäivä 25.11.19, 26.11.19, 28.11.19)
Paahtopaistirieska Pirkka, 135 g (viimeinen käyttöpäivä 22.11.19, 25.11.19, 26.11.19, 28.11.19, 2.12.19, 4.12.19.)
Lidl:n Deli Corner Paahtopaisti 165 g, (viimeinen käyttöpäivä välillä 23.11.–27.11.2019)
Select & Go Kanarulla 220 g, (viimeinen käyttöpäivä välillä 22.11.–28.11.2019)
Seuraavien kohdalla tuotteiden kohdalla tarkempia tuotetietoja eristä on valmistajan sivuilla.
Evertaste Oy / Go! Deli, GO! Deli Paahtopaistirieska kolmioleipä 165g
GO! Deli Juusto-Kinkku kolmioleipä 210g
GO! Deli Kana-Mango kolmioleipä 175g
R-kioskilla myynnissä olevia R-Sandwich Kinkku-Juusto kolmioleipiä, 205g
Fazer Leipomot Oy:n Oululainen Reissumies Eväsleipä Chilikana 135 g
SOK:n Makula Club Wrap 305 g
Listeriariskin vuoksi takaisinvedoista ilmoitettiin edellisen kerran pari päivää sitten: Lidl, Fazer ja Evertaste Oy vetävät tuotteitaan myynnistä listeriaepäilyn vuoksi
Artikkelin aiheet- Osaston luetuimmat